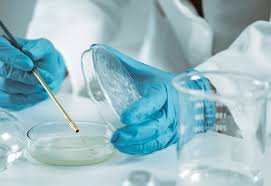
Davos Compact on Antimicrobial Resistance (AMR) 2025

- Nanotechnology is the science, engineering, and application of materials, structures, devices, and systems at the nanoscale, which is typically defined as sizes between 1 and 100 nanometers.
- At this scale, materials exhibit unique physical, chemical, and biological properties that can be used to develop novel materials, devices, and systems with a wide range of applications.
- The concept behind this principle originated in a talk entitled, “There’s Plenty of Room at the Bottom” by physicist Richard Feynman in 1959. The term nanotechnology was actually coined by Professor Norio Taniguchi.
Applications of nanotechnology
- Electronics: Nanotechnology is being used to develop smaller and more powerful electronic devices. For example, nanoscale transistors can be made smaller and more energy-efficient than traditional transistors, leading to faster and more powerful computers and other electronic devices.
- Medicine: Nanotechnology has many potential applications in medicine, such as drug delivery systems and nanoscale sensors for diagnosing diseases. For example, nanoparticles can be engineered to deliver drugs directly to cancer cells, minimizing side effects and improving treatment outcomes.
- Energy: Nanotechnology is being used to develop more efficient solar cells, batteries, and fuel cells. For example, nanoscale materials can be used to increase the surface area of electrodes in batteries and fuel cells, leading to higher energy density and longer lifetimes.
- Materials science: Nanotechnology is being used to develop new materials with unique properties. For example, carbon nanotubes are stronger and more conductive than traditional materials and can be used in a wide range of applications, such as lightweight and strong composites for aircraft and other vehicles.
- Environmental science: Nanotechnology is being used to develop new materials and technologies for cleaning up environmental pollution. For example, nanoparticles can be used to remove heavy metals and other contaminants from water and soil.
Risks with nanotechnology
- Health Risks: Nanoparticles are so small that they can easily enter the body through the lungs, skin, or digestive system. Once inside the body, they can interact with cells and tissues in unpredictable ways. For example, some studies have shown that certain types of nanoparticles can cause lung damage, inflammation, and oxidative stress. Other studies have shown that some nanoparticles can accumulate in the liver, spleen, or other organs, potentially causing long-term health problems.
- Environmental Risks: Nanoparticles can also pose risks to the environment. For example, some nanoparticles can be toxic to aquatic life, such as fish and algae. In addition, nanoparticles can potentially accumulate in the food chain, meaning that they could eventually end up in humans and other animals. For example, some studies have shown that titanium dioxide nanoparticles, which are commonly used in food and cosmetics, can accumulate in the liver and spleen of rats and mice.
- Ethical Risks: Nanotechnology raises ethical questions, particularly in the areas of privacy, security, and human enhancement. For example, the use of nanotechnology in surveillance or military applications could raise concerns about privacy and security. In addition, the use of nanotechnology to enhance human capabilities, such as memory or intelligence, could raise questions about fairness and equality.
- Economic Risks: Nanotechnology has the potential to disrupt traditional industries and create new ones, but there are also economic risks associated with the technology. For example, the high cost of developing and scaling up nanotechnology products could limit their adoption, while the potential for job displacement could create social and economic challenges.
- Societal Risks: Nanotechnology could also have broader societal impacts, such as changing social norms, values, and behaviors. For example, the widespread use of nanotechnology could change our understanding of privacy, or could create new forms of inequality if certain groups have better access to nanotechnology than others.
Evolution of Nanotechnology in India
- Department of Science and Technology (DST): DST is the nodal agency in the Indian nanotechnology innovation system. It has since 1980s launched may programmes/schemes to foster R&D on miniature-scale and on nano-scale.
- 9th Five-Year Plan (1998-2002) had mentioned for the first time that national facilities and core groups were set up to promote research in frontier areas of S&T which included superconductivity, robotics, neurosciences and carbon and nano materials. Planning Commission supported number of such R&D programmes under basic research (GOI 1998).
- The thrust came with the launch of “Programme on Nanomaterials: Science and Devices” in 2000 by the Department of Science and Technology (DST). DST launched special initiative to generate and support some end-to-end projects leading to tangible processes, products and technologies after realising the importance of nanomaterials and their far-reaching impact on technology.
- In 2001-2002, the DST set up an Expert Group on “Nanomaterials: Science and Devices”. The Government identified the need to initiate a Nanomaterials Science and Technology Mission (NSTM) in the 10th Five Year Plan (2002-07) after taking into consideration the developments in nanotechnology. A strategy paper was evolved for supporting on a long-term basis both basic research and application oriented programmes in nanomaterials.
- The National Nanoscience and Nanotechnology Initiative (NSTI) was launched in October, 2001 under the aegis of the Department of Science and Technology of the Ministry of Science. The motive of launching NSTI in 2001 was to create research infrastructure and promote basic research in nanoscience and nanotechnology. It focused on various issues relating to infrastructure development, basic research and application oriented programmes in nanomaterial including drugs/drug delivery/gene targeting and DNA chips.
- On 3 May 2007, a Mission on Nano Science and Technology (Nano Mission) was launched by the DST to foster, promote and develop all aspects of nanoscience and nanotechnology which have the potential to benefit the country.
Achievements of India in field of Nanotech
- The scientists from Banaras Hindu University have devised a simple method to produce carbon nanotube filters that efficiently remove micro-to-nano scale contaminants from water and heavy hydrocarbons from petroleum. Made entirely of carbon, the filters are easily manufactured. The nanotubes composition also makes the filters strong, reusable and heat resistant. They can also be cleared easily for reuse.
- Using the nano sensors, a typhoid detection kit has been developed by Prof. A.K Sood. Also, his student Shankar Ghosh have found that liquid flow in carbon nanotubes can generate electricity current. One of the most exciting applications to emerge from the discovery is the possibility of a heart pacemaker -like device with nanotubes, which will sit in the human body and generate power from the blood.

- A search group headed by Prof. A.N Maitra of the University of Delhi has developed cloven nano patentable technologies for improved drug delivery system using nanoparticle and four of these process have been granted USA, patents one of the important achievements at the initial stage of drug to delivery research was development of a reverse micelles based process for the synthesis of hydrogel and ‘smart’ hydrogel nanoparticles for encapsulating water soluble drugs.
- Development of nanomedicines: Indian researchers have developed several nanomedicines for the treatment of cancer and other diseases. For example, the Indian company Sun Pharma has developed a nanodrug for the treatment of psoriasis, a chronic skin condition. The company claims that the drug is more effective and has fewer side effects than traditional treatments. Additionally, Indian researchers have developed a nanomedicine for the treatment of tuberculosis that has shown promising results in clinical trials.
- Nanotechnology research: India has a strong research base in nanotechnology, with several research institutions and universities working on a wide range of projects. According to the Department of Science and Technology, India published more than 14,000 research papers in nanotechnology between 2015 and 2019. Additionally, the Jawaharlal Nehru Centre for Advanced Scientific Research, Bangalore, is ranked among the top 20 nanotechnology research institutions in the world.
- Nanotechnology for energy: India is using nanotechnology to develop more efficient solar cells and batteries. For example, the Indian company Tata Chemicals has developed a nanotech-based energy storage system that can store energy from renewable sources such as wind and solar. The system uses a nanocomposite material that can store up to 10 times more energy than traditional materials. Additionally, Indian researchers have developed a nanomaterial that can increase the efficiency of solar cells by up to 15%.
- Development of nanosensors: Indian scientists have developed several nanosensors for various applications. For example, a team from the Indian Institute of Technology, Delhi, has developed a nanosensor that can detect the presence of mercury in water. The sensor is based on gold nanoparticles and can detect mercury at concentrations as low as 1 part per billion.
- Commercialization of nanotechnology products: Several Indian companies are commercializing nanotechnology products for various applications. For example, the Indian company Nanoshel has developed a range of nanomaterials for use in the aerospace, automotive, and electronics industries. According to the company, its nanomaterials can improve the strength, durability, and thermal conductivity of materials.

The Indian government has supported activities in nanoscience and nanotechnology in the following ways:
- Activities in nanoscience, nanotechnology, nanobiotechnology, and nanoelectronics are supported by initiatives like MeitY’s CoE in Nanoelectronics, DST-Nanomission (nano-biotechnology activities), and ICMR.
- In the advanced characterization and synthesis of nanomaterials for a variety of applications, the DST has established 18 sophisticated analytical instruments facilities (SAIFs) across India.
- DST-Nanomission’s CoE in Nanoscience and Nanotechnology supports research and graduate students in a variety of thrust areas.
- In product-based research to support nanotechnology, thematic units of excellence (TUEs) for various nanoscience and nanotechnology fields play a significant role.
- MeitY’s Visveswaraya PhD fellowships support various national nanotechnology initiatives.
- The INSPIRE scheme helps research fellows work in areas of nanotechnology, nanoscience, and nanobiotechnology that are interconnected.
- Out of the approximately 70 PG programs that are currently in operation in India, DST-Nanomission provides support to more than 20 of them in order to establish a baseline for nanoscience and nanotechnology in the country.
Challenges
- But there is lot of room for improvement. The amount India spends on nanotechnology research is still just a fraction of the research spending of countries like Japan, USA, France and China.
- The quality of research has shown only a little improvement from the NSTI phase (till 2006) to the nano mission phase (post 2007). Only 16 papers from India appeared in the top 1% of the publications in 2011. Also, the number of patents applied from India to the US patent office contributes to only 0.2% of the total applications.
- Though people look at nanoscience and technology very positively, the number of students following undergraduate and graduate degrees in the area is low and career prospects still extremely limited.
- The number of PhDs awarded in nanoscience and technology is about 150 per year; a very small number compared to the target of producing 10,000 PhD students annually over the next decade articulated by the Ministry of Human Resource Development.
- The contribution of the private sector to nanotechnology research has been minimal. Research from academic institutions has indicated how much impact nanotechnology can have on needs of Indian market. For example, a team from IIT Madras has used nanotechnology for arsenic decontamination of water. Another team from IIT Delhi has come up with a water based self cleaning technology for use in textile industry. It is a matter of concern that, in spite of such enormous potential, the private sector is not investing enough in nanoscience research.
Reforms that could help promote nanotechnology research in India
- Funding: Increased funding for nanotechnology research can help support research institutions and universities working in this field. This can be achieved through increased government funding, partnerships with private industry, and international collaborations.
- Infrastructure: Improved infrastructure and research facilities can help support nanotechnology research in India. This could include building new research centers and upgrading existing facilities, as well as investing in new equipment and technology.
- Education and training: Providing education and training programs for researchers, scientists, and engineers can help build a skilled workforce in the field of nanotechnology. This could include creating specialized degree programs and training courses, as well as providing opportunities for international collaborations and exchange programs.
- Intellectual property protection: Strengthening intellectual property laws and regulations can help protect the intellectual property rights of researchers and companies in the field of nanotechnology. This can help incentivize investment in research and development and promote innovation.
- Regulatory framework: Developing a regulatory framework for nanotechnology can help ensure that nanotechnology products and applications are safe for human health and the environment. This could include developing safety standards and guidelines for nanotechnology research and applications, as well as establishing regulatory bodies to oversee the field.
Conclusion
In the areas of water, clean energy, defense, health, medicine, infrastructure, communications, and other topics of interest, the scientific community, policymakers, apex bodies, and funding agencies are constantly working to advance nanoscience and nanotechnology.
India has made a lot of progress over the past two decades in the fields of nanoelectronics, nanomaterials, and nanobiotechnology, and many more are still to come. It has made numerous researchers of global notoriety in the space of nanoscience and innovation, while numerous youthful personalities are as yet being shaped.